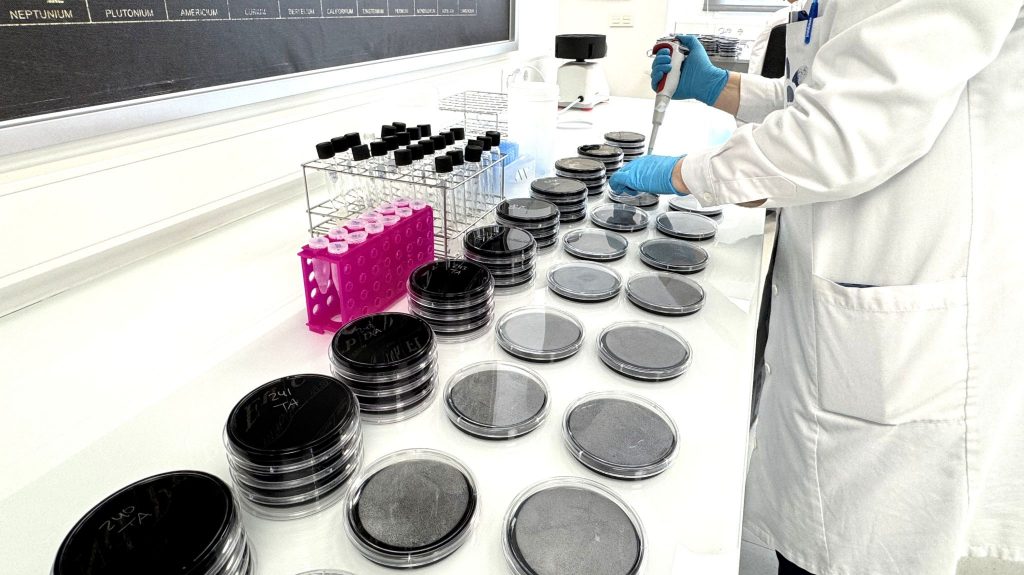
análisis calidad del agua

La calidad del agua es un factor clave para la salud, la seguridad y el correcto funcionamiento de instalaciones industriales, sanitarias y de uso público. Sin embargo, no todos los análisis de agua ofrecen la misma información ni el mismo nivel de fiabilidad.
En Nilsson Laboratorios, abordamos el análisis de la calidad del agua desde una visión integral, evaluando distintos parámetros que nos permiten conocer su estado real, detectar riesgos y garantizar su adecuación a cada uso específico, siempre conforme a la normativa vigente.
¿Qué es el análisis de la calidad del agua y por qué es tan importante?
El análisis de la calidad del agua consiste en el estudio de una serie de parámetros físicos, químicos y microbiológicos que determinan si un agua es segura, estable y apta para su uso.
Estos análisis permiten:
- Detectar contaminaciones visibles e invisibles
- Prevenir riesgos para la salud
- Evaluar el cumplimiento de la legislación sanitaria
- Tomar decisiones correctivas antes de que aparezcan problemas mayores
Análisis fisicoquímico del agua
El análisis fisicoquímico permite conocer las características básicas del agua y detectar alteraciones en su composición.
En Nilsson Laboratorios analizamos parámetros como:
- pH
- Conductividad
- Turbidez
- Color y olor
- Dureza y alcalinidad
- Cloruros y sulfatos
- Nitratos y otros compuestos disueltos
Estos indicadores son fundamentales para identificar:
- Cambios en la calidad del agua
- Procesos de contaminación
- Problemas derivados de instalaciones, tratamientos o captaciones
Análisis microbiológico del agua
El análisis microbiológico del agua es esencial para evaluar su seguridad sanitaria.
En nuestros laboratorios estudiamos la presencia de microorganismos indicadores de contaminación, como:
- Escherichia coli
- Coliformes totales
- Enterococos
Además, realizamos la detección de patógenos específicos como Legionella, especialmente relevante en instalaciones de riesgo, redes de agua sanitaria y sistemas industriales.
Este tipo de análisis es clave para la prevención de enfermedades y el cumplimiento de las exigencias legales en materia de salud pública.
Análisis de metales pesados en agua
El control de metales pesados es otro pilar fundamental en el estudio de la calidad del agua.
En Nilsson Laboratorios determinamos la presencia de elementos como:
- Plomo
- Mercurio
- Cadmio
- Arsénico
- Aluminio
- Hierro, entre otros
Incluso en concentraciones bajas, estos metales pueden tener efectos adversos en la salud, por lo que su vigilancia es imprescindible tanto en aguas de consumo como en aguas de uso industrial.
Un enfoque integral para el control de la calidad del agua
La combinación del análisis fisicoquímico, microbiológico y de metales pesados nos permite ofrecer una evaluación completa y fiable del estado del agua.
Este enfoque integral nos ayuda a:
- Detectar riesgos reales
- Adaptar los análisis a cada necesidad
- Garantizar el cumplimiento normativo
- Ofrecer resultados claros y útiles para la toma de decisiones
En Nilsson Laboratorios, trabajamos para que cada análisis de agua aporte seguridad, confianza y rigor técnico a nuestros clientes.